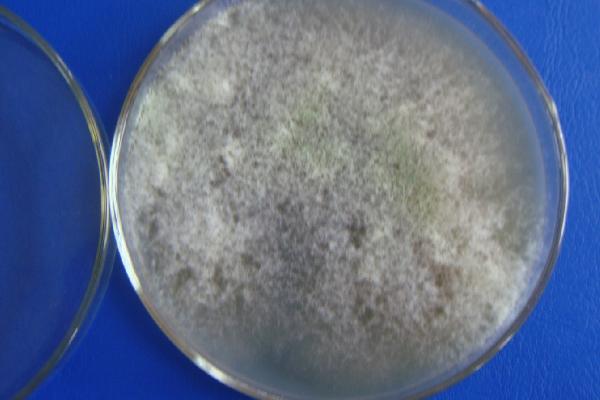
木霉菌如何防治病害,可寄生在病菌上、使其细胞壁破裂

竞争:木霉菌生长速度快、生命力强,可与其他病菌争夺繁衍所需资源。
寄生:木霉菌可寄生于腐霉菌、疫霉菌、立枯丝核菌、霜霉菌等病菌上,然后接侵入或缠绕于菌丝上,致使细胞壁破裂。
协同拮抗:木霉菌可产生蛋白或胞壁降解酶类来抑制病原菌生长繁殖。
诱导抗性:木霉菌可诱导寄主植物产生防御反应,从而获得局部或系统抗病性。

一、木霉菌如何防治病害
1、木霉菌简介
(1)木霉菌属于半知菌类的丝孢纲、丛梗孢目、丛梗孢科,地球上已知的大概有80多种木霉菌,可以快速产生孢子,可以市场化的主要有哈茨木霉、深绿木霉、长枝木霉菌、短密木霉等。
(2)木霉菌可产生许多对植物病原、及昆虫具有拮抗作用的生物活性物质从而达到防病、治病的效果,而且还能促进生长、提高养分利用率、增强作物抗逆性和修护农化环境污染等。
2、防治原理
(1)竞争作用
木霉菌生长速度快、生命力强,能迅速占领生长空间,吸收所需营养,削弱和排除同一生长环境中其他病原物。
(2)重寄生作用
木霉菌可以寄生于腐霉菌、疫霉菌、立枯丝核菌、霜霉菌等约18属。它们直接侵入或缠绕在菌丝上,引起病原菌细胞膨大、变形、缩短、变圆、原生质收缩,细胞壁破裂。
(3)协同拮抗作用
木霉菌通过产生小分子的和大分子的蛋白或胞壁降解酶类来抑制病原菌的生长、繁殖和侵染。木霉菌的拮抗作用可能是二种或三种生防机制同时或顺次作用的综合。
(4)诱导抗性作用
①木霉菌可以诱导寄主植物产生防御反应,在抑制病菌生长和繁殖的同时,还能诱导作物产生自我防御系统获得局部或系统抗病性。
②目前已报道木霉菌的防治对象寄主主要有:土豆、花生、菜豆、大豆、牛豆、豌豆、黄瓜、西瓜、番茄、辣椒、茄子、草莓、葡萄、苹果、柑桔、甜菜、油菜、百合等。

二、木霉菌不能与什么药物混配
1、除了呈碱性的农药与铜制剂以外,木霉菌类药剂可以与多数生物杀虫剂和化学杀虫剂同时混用。
2、木霉菌和杀菌剂的组合应用可以增强药效,同时可以减少杀菌剂的用量,从而降低环境污染,减少农药残留量,减轻对环境中有益微生物的破坏。

3、近些年,木霉菌的研究与应用得到了快速的发展。结合遗传学、分子生物学、生物化学及生态学等研究方法,木霉菌及其代谢产物在促进植物生长,增加营养物质的吸收利用率,提高农作物的产量,以及增强对病害的防御性方面势必有更为广阔的应用前景。
4、特别是在倡导绿色农业的大背景下,木霉菌的大面积推广应用已成为构建现代和高效的生物防治病虫害体系中不可或缺的一部分。


